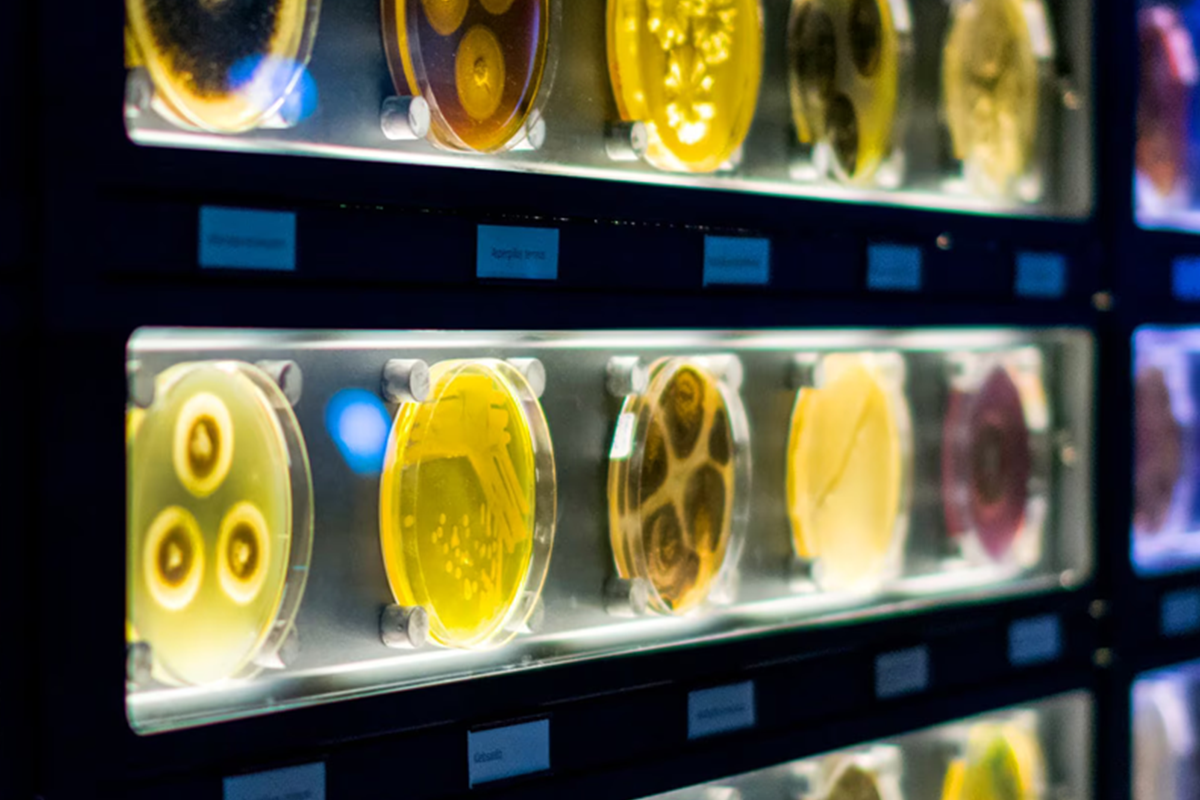
ARTIS-MICROPIA Ticket

ARTIS-MICROPIA Ticket
ARTIS-MICROPIA Ticket
Ontdek de onzichtbare wereld bij ARTIS-Micropia! Bezoek de expositie MAGNIFIED, ontmoet microben en luister naar verhalen van laboranten.

Tickets direct beschikbaar

Tickets scanbaar vanaf je smartphone
Wat te verwachten
- ARTIS-MICROPIA Ticket, 13+ (t.w.v. €17,50)
- Gratis toegang voor kinderen t/m 12 jaar
- Bezoek ’s wereld enige microbenmuseum in hartje Amsterdam
- Tijdelijke expositie: MAGNIFIED. Ontdek de wereld door de microscoop
- Elke maand een nieuwe microbe van de maand
- Luister naar de verhalen van de laboranten
- Verzamel alle microbenstempels in het museum
Voorwaarden
- Geldigheid: eenmalig geldig op een door jou gekozen datum t/m uiterlijk 15 maart 2026
- Ticket: na aankoop kun je je e-ticket downloaden
- Toegang: neem op de dag van je bezoek je e-ticket digitaal of geprint mee
- Honden en andere huisdieren zijn niet toegestaan in ARTIS
Meer informatie
ARTIS-Micropia is het eerste en enige museum ter wereld dat volledig gewijd is aan microben. Ze zijn overal: in de lucht, op je huid, in je buik. Ze maken eten lekker, houden je gezond en zorgen voor balans in de natuur. Microben zijn onmisbaar.
Toch kun je dit onzichtbare leven alleen zien met een microscoop. De tentoonstelling MAGNIFIED laat zien hoe microscopen onze blik op de wereld voor altijd veranderd hebben. Van de eerste lenzen tot haarscherpe beelden. Bekijk microben in beeld, spel en verhaal.
Neem eens een kijkje in de agenda van Micropia. Hier staan dagelijks activiteiten vermeld zoals het praatje van de laborant.
Bereikbaarheid & parkeren
Met het openbaar vervoer
- Tram: Tram 14 (Amsterdam Centraal - Flevopark) stopt bij de halte ARTIS, direct om de hoek van de Hoofdentree. Trams 7 (Slotermeer - Azartplein) en 19 (Station Sloterdijk - Diemen Sniep) stoppen op het Alexanderplein, op tien minuten loopafstand van de Hoofdentree.
- Metro: Het dichtstbijzijnde metrostation is Waterlooplein. Metro's 51, 53 en 54 rijden vanaf Amsterdam Centraal hierheen. Vanaf het metrostation is het nog tien minuten lopen naar de Hoofdentree.
- Bus: Vanaf Amsterdam Centraal rijden bussen 22 en 43 naar het Kadijksplein. Vanaf daar is het zes minuten lopen naar de Hoofdentree.
Met de auto
- ARTIS beschikt over een parkeerterrein. Parkeerticket is te koop bij de kassa.